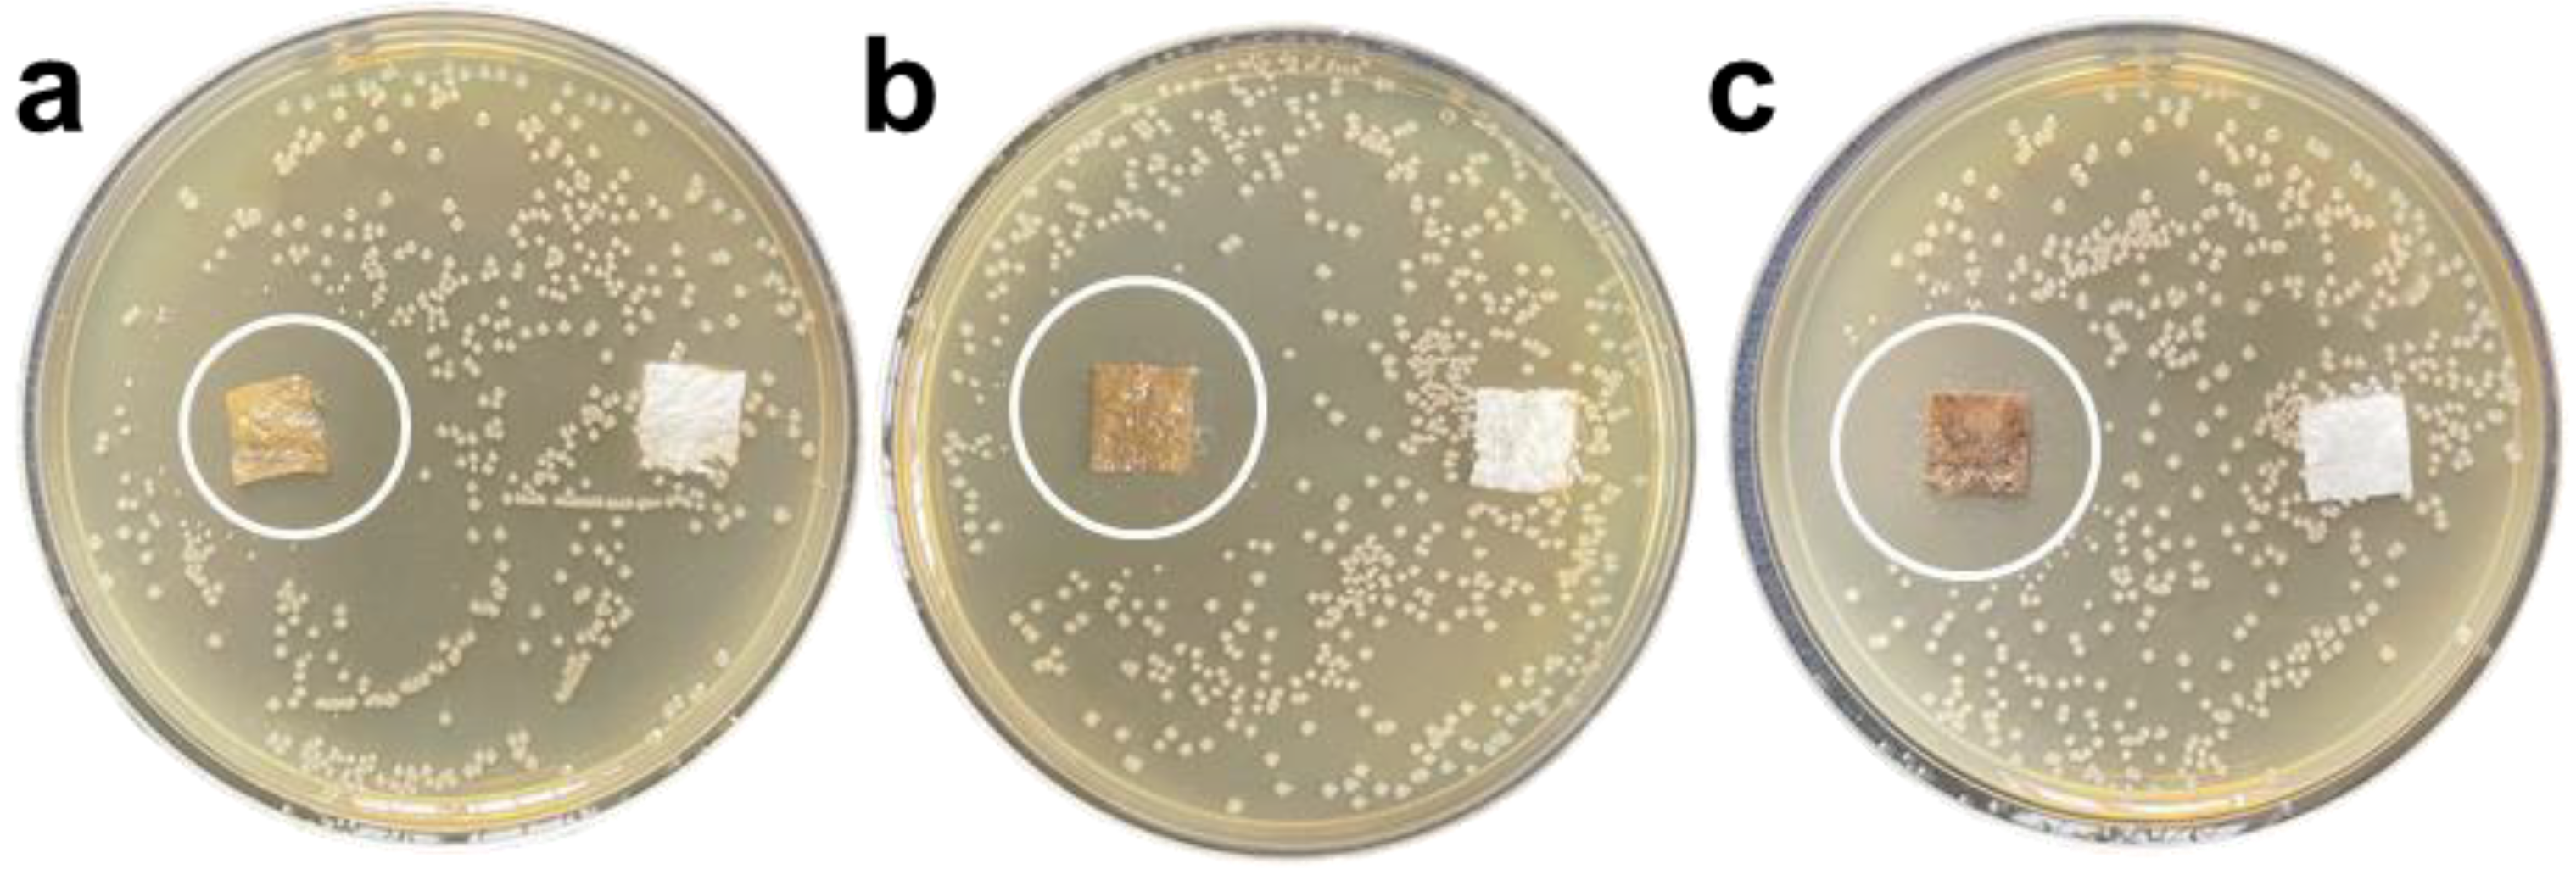
Nanomaterials 12 01857 g005

Antibacterial Activity and Mechanism of GO/Cu2O/ZnO Coating on Ultrafine Glass Fiber
Abstract
:1. Introduction
2. Experimental Details
3. Results and Discussion
3.1. Morphological Analysis of GO/ZnO/Cu2O Antibacterial Powder
3.2. Structural and Optical Analysis of GO/ZnO/Cu2O Antibacterial Powder
3.3. Antibacterial Properties

3.4. Photocatalysis/Oxidative Stress Mechanism



4. Conclusions
- (1)
- The HRTEM images of the GZC antibacterial powder show that the two-dimensional lamellar structure of graphene oxide can support ZnO and Cu2O particles relatively uniformly, and its loose and porous structure can play a good role in antibacterial and slow release.
- (2)
- FTIR showed that after GO was compounded with ZnO and Cu2O, the structure of each component did not change significantly, and no new functional groups were introduced.
- (3)
- S. aureus reached 100% inhibition rate after exposure for 12 h; with the increase in the antibacterial coating concentration, its inhibition zone against E. coli and S. aureus gradually expanded, and the antibacterial effect on S. aureus increased better than E. coli. The application feasibility of the antibacterial coating was preliminarily verified.
- (4)
- This research focuses on the antibacterial mechanism of GZC antibacterial powder, puts forward hypotheses based on existing data, uses relevant test methods in the field of photoelectrochemistry to verify and analyze, and, finally, summarizes the photocatalysis/oxidative stress mechanism.
Supplementary Materials
Author Contributions
Funding
Institutional Review Board Statement
Informed Consent Statement
Data Availability Statement
Acknowledgments
Conflicts of Interest
References
- Innocenzi, P.; Stagi, L. Carbon-based Antiviral Nanomaterials, Graphene, C-dots, Fullerenes. A perspective. Chem. Sci. 2020, 11, 6606–6622. [Google Scholar] [CrossRef] [PubMed]
- Menazea, A.; Ahmed, M. Synthesis and antibacterial activity of graphene oxide decorated by silver and copper oxide nanoparticles. J. Mol. Struct. 2020, 1218, 128536. [Google Scholar] [CrossRef]
- Ahmed, M.; Al-Wafi, R.; Mansour, S.; El-Dek, S.; Uskoković, V. Physical and biological changes associated with the doping of carbonated hydroxyapatite/polycaprolactone core-shell nanofibers dually, with rubidium and selenite. J. Mater. Res. Technol. 2020, 9, 3710–3723. [Google Scholar] [CrossRef]
- Mansour, S.F.; Al-Wafi, R.; Ahmed, M.K.; Wageh, S. Microstructural, morphological behavior and removal of Cr(VI) and Se(IV) from aqueous solutions by magnetite nanoparticles/PVA and cellulose acetate nanofibers. Appl. Phys. A 2020, 126, 204. [Google Scholar] [CrossRef]
- Menazea, A.A.; Abdelghany, A.M.; Hakeem, N.A.; Osman, W.H.; El-Kader, F.H.A. Precipitation of Silver Nanoparticles in Borate Glasses by 1064 nm Nd:YAG Nanosecond Laser Pulses: Characterization and Dielectric Studies. J. Electron. Mater. 2019, 49, 826–832. [Google Scholar] [CrossRef]
- Samy, A.; El-Sherbiny, A.; Menazea, A.A. Green synthesis of high impact zinc oxide nanoparticles. Egypt. J. Chem. 2019, 62, 29–37. [Google Scholar] [CrossRef] [Green Version]
- Ahmed, M.; Mansour, S.; Al-Wafi, R.; Afifi, M.; Uskoković, V. Gold as a dopant in selenium-containing carbonated hydroxyapatite fillers of nanofibrous ε-polycaprolactone scaffolds for tissue engineering. Int. J. Pharm. 2019, 577, 118950. [Google Scholar] [CrossRef]
- Menazea, A.; Mostafa, A.M.; Al-Ashkar, E.A. Effect of nanostructured metal oxides (CdO, Al2O3, Cu2O) embedded in PVA via Nd:YAG pulsed laser ablation on their optical and structural properties. J. Mol. Struct. 2020, 1203, 127374. [Google Scholar] [CrossRef]
- Menazea, A.; Ismail, A.; Elashmawi, I. The role of Li4Ti5O12 nanoparticles on enhancement the performance of PVDF/PVK blend for lithium-ion batteries. J. Mater. Res. Technol. 2020, 9, 5689–5698. [Google Scholar] [CrossRef]
- Alam, S.N.; Sharma, N.; Kumar, L. Synthesis of Graphene Oxide (GO) by Modified Hummers Method and Its Thermal Reduction to Obtain Reduced Graphene Oxide (rGO). Graphene 2017, 6, 1–18. [Google Scholar] [CrossRef] [Green Version]
- Su, Y.; Prestat, E.; Hu, C.; Puthiyapura, V.K.; Neek-Amal, M.; Xiao, H.; Huang, K.; Kravets, V.G.; Haigh, S.J.; Hardacre, C.; et al. Self-Limiting Growth of Two-Dimensional Palladium between Graphene Oxide Layers. Nano Lett. 2019, 19, 4678–4683. [Google Scholar] [CrossRef] [PubMed]
- Ahmed, M.K.; Mansour, S.F.; Al-Wafi, R. Nanofibrous scaffolds of ϵ-polycaprolactone containing Sr/Se-hydroxyapatite/graphene oxide for tissue engineering applications. Biomed. Mater. 2021, 16, 045030. [Google Scholar] [CrossRef] [PubMed]
- Ahmed, M.; Mansour, S.; Al-Wafi, R.; Menazea, A. Composition and design of nanofibrous scaffolds of Mg/Se- hydroxyapatite/graphene oxide @ ε-polycaprolactone for wound healing applications. J. Mater. Res. Technol. 2020, 9, 7472–7485. [Google Scholar] [CrossRef]
- Menazea, A.; Ahmed, M. Wound healing activity of Chitosan/Polyvinyl Alcohol embedded by gold nanoparticles prepared by nanosecond laser ablation. J. Mol. Struct. 2020, 1217, 128401. [Google Scholar] [CrossRef]
- Al-Wafi, R.; Mansour, S.; Ahmed, M. Mechanical, microstructural properties and cell adhesion of Sr/Se-hydroxyapatite/graphene/polycaprolactone nanofibers. J. Thermoplast. Compos. Mater. 2021, 34, 536–556. [Google Scholar] [CrossRef]
- Liang, F.-X.; Gao, Y.; Xie, C.; Tong, X.-W.; Li, Z.-J.; Luo, L.-B. Recent advances in the fabrication of graphene–ZnO heterojunctions for optoelectronic device applications. J. Mater. Chem. C 2018, 6, 3815–3833. [Google Scholar] [CrossRef]
- Geim, A.K.; Novoselov, K.S. The rise of graphene. Nat. Mater. 2007, 6, 183–191. [Google Scholar] [CrossRef] [PubMed]
- Liu, L.; Wang, L.; Gao, J.; Zhao, J.; Gao, X.; Chen, Z. Amorphous structural models for graphene oxides. Carbon 2012, 50, 1690–1698. [Google Scholar] [CrossRef]
- Ji, X.; Xu, Y.; Zhang, W.; Cui, L.; Liu, J. Review of functionalization, structure and properties of graphene/polymer composite fibers. Compos. Part A 2016, 87, 29–45. [Google Scholar] [CrossRef]
- Zhu, Q.-L.; Xu, Q. Immobilization of Ultrafine Metal Nanoparticles to High-Surface-Area Materials and Their Catalytic Applications. Chem 2016, 1, 220–245. [Google Scholar] [CrossRef]
- Li, M.; Chen, Z.; Sun, Y.; Wang, F.; Wu, C.; Xu, J.; Zhang, J. Preparation and antibacterial activity of graphene oxide/cuprous oxide/zinc oxide nanocomposite. Mater. Res. Express 2021, 8, 125003. [Google Scholar] [CrossRef]
- Gupta, S.; Banaszak, A.; Smith, T.; Dimakis, N. Molecular sensitivity of metal nanoparticles decorated graphene-family nanomaterials as surface-enhanced Raman scattering (SERS) platforms. J. Raman Spectrosc. 2017, 49, 438–451. [Google Scholar] [CrossRef]
- Abboud, Y.; Saffaj, T.; Chagraoui, A.; El Bouari, A.; Brouzi, K.; Tanane, O.; Ihssane, B. Biosynthesis, characterization and an-timicrobial activity of copper oxide nanoparticles (CONPs) produced using brown alga extract (Bifurcaria bifurcata). Appl. Nanosci. 2014, 4, 571–576. [Google Scholar] [CrossRef] [Green Version]
- Ahmed, K.B.A.; Raman, T.; Anbazhagan, V. Platinum nanoparticles inhibit bacteria proliferation and rescue zebrafish from bacterial infection. RSC Adv. 2016, 6, 44415–44424. [Google Scholar] [CrossRef]
- Sikora, P.; Augustyniak, A.; Cendrowski, K.; Nawrotek, P.; Mijowska, E. Antimicrobial Activity of Al2O3, CuO, Fe3O4, and ZnO Nanoparticles in Scope of Their Further Application in Cement-Based Building Materials. Nanomaterials 2018, 8, 212. [Google Scholar] [CrossRef] [PubMed] [Green Version]
- Nguyen, N.-Y.T.; Grelling, N.; Wetteland, C.L.; Rosario, R.; Liu, H.N. Antimicrobial Activities and Mechanisms of Magnesium Oxide Nanoparticles (nMgO) against Pathogenic Bacteria, Yeasts, and Biofilms. Sci. Rep. 2018, 8, 16260. [Google Scholar] [CrossRef] [PubMed] [Green Version]
- Karthik, A.D.; Geetha, K. Synthesis of copper precursor, copper and its oxide nanoparticles by green chemical reduction method and its antimicrobial activity. J. Appl. Pharm. Sci. 2011, 3, 016–021. [Google Scholar]
- Sirelkhatim, A.; Mahmud, S.; Seeni, A.; Kaus, N.H.M.; Ann, L.C.; Bakhori, S.K.M.; Hasan, H.; Mohamad, D. Review on Zinc Oxide Nanoparticles: Antibacterial Activity and Toxicity Mechanism. Nano-Micro Lett. 2015, 7, 219–242. [Google Scholar] [CrossRef] [Green Version]
- Shaheen, T.I.; El-Naggar, M.E.; Abdelgawad, A.; Hebeish, A. Durable antibacterial and UV protections of in situ synthesized zinc oxide nanoparticles onto cotton fabrics. Int. J. Biol. Macromol. 2016, 83, 426–432. [Google Scholar] [CrossRef]
- Zhang, Y.; Nayak, T.; Hong, H.; Cai, W. Biomedical Applications of Zinc Oxide Nanomaterials. Curr. Mol. Med. 2013, 13, 1633–1645. [Google Scholar] [CrossRef] [Green Version]
- Chang, T.; Li, Z.; Yun, G.; Jia, Y.; Yang, H. Enhanced Photocatalytic Activity of ZnO/CuO Nanocomposites Synthesized by Hydrothermal Method. Nano-Micro Lett. 2013, 5, 163–168. [Google Scholar] [CrossRef]
- Zhou, Y.; Chen, G.; Yu, Y.; Hao, L.; Han, Z.; Yu, Q. Oxygen functional groups induced formation of Cu2O nanoparticles on the surface of reduced graphene oxide. New J. Chem. 2013, 37, 2845–2850. [Google Scholar] [CrossRef]
- Razali, R.; Zak, A.K.; Majid, W.A.; Darroudi, M. Solvothermal synthesis of microsphere ZnO nanostructures in DEA media. Ceram. Int. 2011, 37, 3657–3663. [Google Scholar] [CrossRef]
- Siddiqui, H.; Qureshi, M.S.; Haque, F.Z. Biosynthesis of Flower-Shaped CuO Nanostructures and Their Photocatalytic and Antibacterial Activities. Nano-Micro Lett. 2020, 12, 29. [Google Scholar] [CrossRef] [PubMed] [Green Version]
- Kumar, K.M.; Mandal, B.K.; Naidu, E.A.; Sinha, M.; Kumar, K.S.; Reddy, P.S. Synthesis and characterisation of flower shaped Zinc Oxide nanostructures and its antimicrobial activity. Spectrochim. Acta Part A Mol. Biomol. Spectrosc. 2013, 104, 171–174. [Google Scholar] [CrossRef]
- Wang, M.; Huang, J.; Tong, Z.; Li, W.; Chen, J. Reduced graphene oxide–cuprous oxide composite via facial deposition for photocatalytic dye-degradation. J. Alloys Compd. 2013, 568, 26–35. [Google Scholar] [CrossRef]
- Huang, H.; Velmurugan, M.; Manibalan, K.; Zhang, Q.; Lu, X.; Wang, Y.; Lin, J.-M. Synthesis and Antibacterial Activity Investigation of Novel Cuprous Oxide-Graphene Oxide Nanocomposites. Chem. Lett. 2020, 49, 693–696. [Google Scholar] [CrossRef]
- Ganguly, S.; Das, P.; Bose, M.; Das, T.K.; Mondal, S.; Das, A.K.; Das, N.C. Sonochemical green reduction to prepare Ag nanoparticles decorated graphene sheets for catalytic performance and antibacterial application. Ultrason. Sonochemistry 2017, 39, 577–588. [Google Scholar] [CrossRef]
- Wu, M.; Yan, L.; Xu, M.; Zhu, Y.; Li, Y.; Sun, X.; Xu, R.; Yang, J. Preparation of composite graphene hydrogels adsorbent with special-shaped ZnO and TiO2. Colloids Surfaces A 2019, 581, 123783. [Google Scholar] [CrossRef]
- Hernández, C.N.; García, M.B.G.; Santos, D.H.; Heras, M.A.; Colina, A.; Fanjul-Bolado, P. Aqueous UV–VIS spectroelectrochemical study of the voltammetric reduction of graphene oxide on screen-printed carbon electrodes. Electrochem. Commun. 2016, 64, 65–68. [Google Scholar] [CrossRef] [Green Version]
- Kulshrestha, S.; Khan, S.; Meena, R.; Singh, B.R.; Khan, A.U. A graphene/zinc oxide nanocomposite film protects dental implant surfaces against cariogenic Streptococcus mutans. Biofouling 2014, 30, 1281–1294. [Google Scholar] [CrossRef] [PubMed]
- Liu, Q.; Cao, F.; Wu, F.; Lu, H.; Li, L. Ultrathin Amorphous Ni(OH)2 Nanosheets on Ultrathin α-Fe2O3 Films for Improved Photoelectrochemical Water Oxidation. Adv. Mater. Interfaces 2016, 3, 1600256. [Google Scholar] [CrossRef]
- Bai, X.; Wang, L.; Wang, Y.; Yao, W.; Zhu, Y. Enhanced oxidation ability of g-C3N4 photocatalyst via C60 modification. Appl. Catal. B Environ. 2014, 152–153, 262–270. [Google Scholar] [CrossRef]
- Zhang, L.; Chen, P.; Xu, Y.; Nie, W.; Zhou, Y. Enhanced photo-induced antibacterial application of graphene oxide modified by sodium anthraquinone-2-sulfonate under visible light. Appl. Catal. B Environ. 2020, 265, 118572–118581. [Google Scholar] [CrossRef]

| Sample Serial Number | Clump Count/Indivual | Antibacterial Ratio/% | |
|---|---|---|---|
| E. coli | GZC-1 | 0 | 100 |
| GZC-2 | 0 | 100 | |
| GZC-3 | 0 | 100 | |
| Control group | 630 | / | |
| S. aureus | GZC-1 | 0 | 100 |
| GZC-2 | 0 | 100 | |
| GZC-3 | 0 | 100 | |
| Control group | 210 | / |
Publisher’s Note: MDPI stays neutral with regard to jurisdictional claims in published maps and institutional affiliations. |
© 2022 by the authors. Licensee MDPI, Basel, Switzerland. This article is an open access article distributed under the terms and conditions of the Creative Commons Attribution (CC BY) license (https://creativecommons.org/licenses/by/4.0/).
Share and Cite
Li, M.; Chen, Z.; Yang, L.; Li, J.; Xu, J.; Chen, C.; Wu, Q.; Yang, M.; Liu, T. Antibacterial Activity and Mechanism of GO/Cu2O/ZnO Coating on Ultrafine Glass Fiber. Nanomaterials 2022, 12, 1857. https://doi.org/10.3390/nano12111857
Li M, Chen Z, Yang L, Li J, Xu J, Chen C, Wu Q, Yang M, Liu T. Antibacterial Activity and Mechanism of GO/Cu2O/ZnO Coating on Ultrafine Glass Fiber. Nanomaterials. 2022; 12(11):1857. https://doi.org/10.3390/nano12111857
Chicago/Turabian StyleLi, Manna, Zhaofeng Chen, Lixia Yang, Jiayu Li, Jiang Xu, Chao Chen, Qiong Wu, Mengmeng Yang, and Tianlong Liu. 2022. "Antibacterial Activity and Mechanism of GO/Cu2O/ZnO Coating on Ultrafine Glass Fiber" Nanomaterials 12, no. 11: 1857. https://doi.org/10.3390/nano12111857
APA StyleLi, M., Chen, Z., Yang, L., Li, J., Xu, J., Chen, C., Wu, Q., Yang, M., & Liu, T. (2022). Antibacterial Activity and Mechanism of GO/Cu2O/ZnO Coating on Ultrafine Glass Fiber. Nanomaterials, 12(11), 1857. https://doi.org/10.3390/nano12111857








